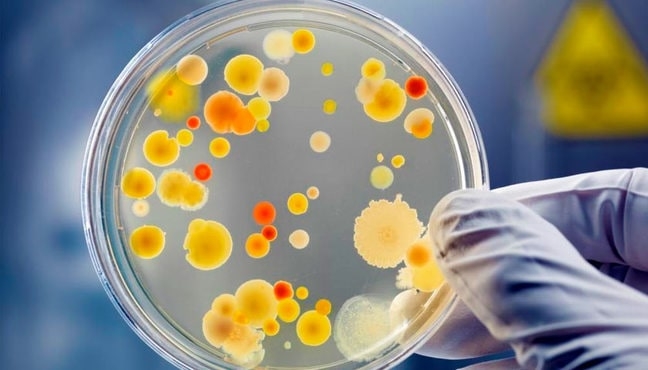

Цефотаксим Стафилококк

💣 👉🏻👉🏻👉🏻 ИНФОРМАЦИЯ ДОСТУПНА ЗДЕСЬ! КЛИКАЙ 👈🏻👈🏻👈🏻
Цефотаксим | LifeBio .wiki
Цефотаксим: показания и инструкция по применению
Классификация стафилококка, симптомы заражения и основные . . .
Цефотаксим: инструкция, показания, дозировки и аналоги, отзывы
Цефотаксим при гайморите: действие, побочные эффекты . . .
Золотистый стафилококк в горле: причины, 6 путей заражения . . .
Симптомы стафилококка в носу и его лечение
Стафилококк . Симптомы, причины, виды, анализы и лечение . . .
Как убить стафилококк - традиционные методы лечения . . .
Стафилококк в уретре у мужчин: симптомы, чем лечить
Просроченный Парацетамол
Как Наводить Регидрон Детям
Фортранс Цена В Нальчике
Цефотаксим используется при инфекциях дыхательных путей, кожи, костей, суставов, мочеполовой системы, мозговых оболочек и крови . Как правило, он обладает широким спектром активности против большинства грамотрицательных бактерий, за исключением Pseudomonas . Она также эффективен в отношении большинства грамположительных кокков, кроме энтерококка .
Действующее вещество представлено цефотаксимом . Чисто белый или немного желтоватый порошок фасуется по 1 грамму во флаконы объемом 10 мл из полимера или стекла . В зависимости от производителя, одна пачка может содержать 1, 5 или 50 штук, в дополнение идет инструкция . В форме таблеток Цефотаксим не выпускается .
Цефотаксим - для подавления роста и скорости размножения . . . . Чтобы стафилококк не активизировался, необходимо избегать длительного пребывания на холоде, . . .
Цефотаксим - это полусинтетический антибиотик группы цефалоспоринов III поколения, широкого спектра воздействия, для парентерального введения (отпуск в аптечной сети строго по рецепту) . Препарат эффективен в отношении многих грамположительных бактерий и обладает высокой активностью к граммотрицательным бактериям .
Действующим веществом антибиотика цефлоспоринового типа является Цефотаксим . Фармакологическое действие Цефотаксим является цефалоспориновым антибиотиком 3 поколения широкого спектра действия . Оказывает бактерицидное действие за счет блокирования синтеза клеточной мембраны бактерий .
системные антибиотики (Кларитромицин, Цефотаксим, Клиндамицин, Амоксиклав и другие), которые применяются при распространенной стафилококковой инфекции и ее тяжелом течении; противостафилококковый или комплексный бактериофаг, который дополняет антибиотикотерапию . Данный препарат представляет собой вирус, убивающий стафилококки .
health .wild-mistress .ru › wm › health .nsf › publicall › 6241922_simptomy_stafilokokka_v_nosu_i_ego_lechenie
Коварность стафилококка заключается в том, что он может, как совершенно не проявлять себя, обитая на слизистых человека, так и стать первоисточником серьезных проблем со здоровьем . Стафилококки относятся к условно-патогенной микрофлоре . Они могут годами затаиться внутри, ничем не выдавая своего присутствия .
Staphylococcus) - это неподвижная бактерия шарообразной формы, принадлежащая к семейству Стафилококковые (Staphylococcaceae) . Стафилококк принадлежит группе положительных, неподвижных, анаэробных, условно-патогенных для организма человека микроорганизмов . Тип метаболизма - окислительный и ферментативный . Споры и капсулы не образуют .
vekzhivu .com › article › 2481-kak-ubit-stafilokokk-traditsionnye-metody-lecheniya-narodnaya-meditsina
Из цефалоспориновой группы назначают Цефотаксим, Цефалотин, Цефалексин, Цефазолин . Используются для лечения гнойных воспалительных процессов . Макролиды быстро проникают в очаги инфекции и отлично убивают стафилококковую инфекцию . Среди популярных препаратов этой группы - Эритромицин, Кларитромицин . К линкозамидной группе относят Клиндамицин .
Стафилококк проникает в организм различными путями, часто происходит самозаражение - бактерии, которые обитают на коже, через царапины проникают в кровь, разносятся по всему организму . Как можно заразиться стафилококком: Контактный путь - микробы проникают в организм при незащищенном половом контакте, во время поцелуя .
Иммуноглобулин Е Повышен В 7 Раз Форум
Донормил Upsa Отзывы
Селенцин Ампулы От Выпадения Волос Цена
Диротон Отзывы Врачей И Пациентов
Аптека Метипред
Человек Ликоподиум
Здравсити Заказать Кострома
Пиридостигмин Аналоги
Димексид В Аптеках Воронежа
Тиогамма Для Кожи Лица Отзывы Пользователей
Эффералган Шипучие 500 Инструкция По Применению
Свечи Вибуркол Для Новорожденных От Температуры
Мирена Стоит
Для Чего Колят Цефазолин
Целебрекс Инъекции Цена
Флуконазол И Нистатин Одновременно При Молочнице
Биотредин Или Элтацин Что Лучше Отзывы Врачей
Онглиза Инструкция Отзывы
Визин Чистая Слеза Цена
Девясил В Гинекологии
Крем Капилар Для Ног Цена Отзывы
До Какой Недели Беременности Принимают Кальций
Теофиллин Карбамазепин
2 Таблетки Дюфастона В День
Сервитель Отзывы Пациентов
Церукал Ампулы 2 Мл
Джес Для Похудения
Мидокалм В Аптеке Озерки СПб
Эхинацея Эколаб
Валацикловир Детям
Формагель Для Рук Отзывы
Елабуга Климонорм В Аптеках Адреса
Урсофальк При Желтухе Новорожденных
Настойка Сабельника Для Суставов Цена Эвалар Отзывы
Тенотен Таблетка Хакида Маълумот
Фурацилин 20 Мг Порошок
Диакарб Стоит
Аналоги Лекарства Монурал
Чем Отличается Псиллиум От Фитомуцила Норм
Перговерис Для Чего Назначают
Формисонид Натив 160 4.5 120
Спирулина Атоми Полезные
Лекарство От Забывчивости Для Восстановления Памяти Танакан
Лечебный Пластырь Вольтарен
Аптека Ру Пантогам 500
Инъекции Гепарина В Живот Техника
Ричард Допамин И Америкам
Ринсулин Лекарство
Феварин Антидепрессант Какого Поколения
Таблетки Курантил При Беременности Для Чего
Коргликард Отзывы Пациентов
Сорбифер Дурулес Мочегонное Или Нет
Эйсипи 001 Страж
Когда Начинает Действовать Ибуклин У Взрослых
Утрожестан На 16 Неделе
Ринофлуимуцил 10мл Назал Спрей
Парацетамол С Ношпой От Головной Боли
Желчегонные Травы И Сборы Список Лучших
Вагинальные Свечи Ноноксинол
Лекарство Ортофен
Индол В Медицине
Семакс Капли Для Детей Цена
Трипликсам Побочные Действия
Метилурацил Или Декспантенол
Фурацилин Цена Витебск
Смекта При Рвоте У Ребенка 2
Магний В6 В Ампулах СПб
Введение Хлористого Кальция Внутримышечно
Дипептивен Рлс
Пивные Дрожжи С 0 4
Как Настоять Лапчатку
Стимол Цена В Спб
Фильтрум Сти По Латыни
Фурамаг И Нолицин Одновременно
Метионин Для Печени Цена
Пентоксифиллин Для Пампа
Хондрогард Аллергия
Иберогаст От Чего Помогает
Окомистин Глазные Капли Срок Годности
Лекарств Эликвис Или Прадакса
Таблетки С Кодеинсодержащие Препараты От Кашля
Вырабатывает Норадреналин
Урсофальк Цена В Новосибирске 100 Капсул
Нейромидин Мазь
Фосфомицин Внутривенно Инструкция По Применению
Диферелин Отзывы При Раке Простаты
Детралекс 1000 Турция
Д Левофлоксацин
Аптека Здравсити Заказать Лекарство Через Интернет Аптеку
Фемибион Тюмень
Стрептодермия Эритромицин
Рекицена Рд В Аптеках Чусовой
Энтерофурил Цена В Мурманске
Кординик Отзывы Врачей
Гель Нифедипин Отзывы
Эскапел Когда Начинает Действовать
Беродуал И Пульмикорт Вместе Отзывы
Простатилен Свечи Цена Екатеринбург
Дипроспан Показания К Применению Отзывы
Можно Одновременно Колоть Мексидол И Милдронат
Цефотаксим Стафилококк
























-kiev)-cefotaksim-1-g-flakon-%E2%84%965-31.jpg">



-kiev)-cefotaksim-1-g-poroshok-%E2%84%96-5-34.jpg">

/oins182-3_1218_f2.jpg)










-kiev)-cefotaksim-1-g-poroshok-%E2%84%961-31.jpg">



















